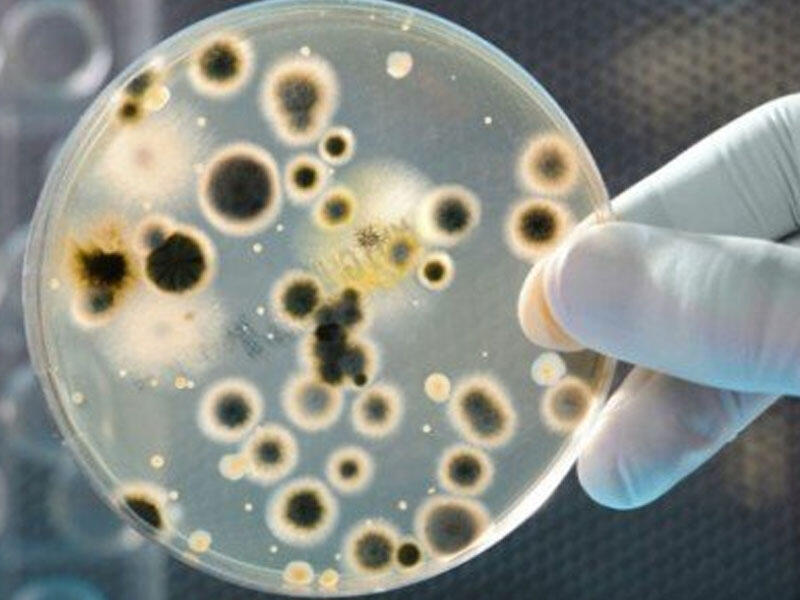

Ümumdünya Səhiyyə Təşkilatı xəbərdarlıq edir ki, 2050-ci ilə qədər antibiotiklər bir çox bakteriayalara təsir etməyəcək (buna "rezistentlik" deyilir).
Bu səbəbdən dünyada bu bakteriyalar tərəfindən törədilən xəstəliklərdən milyonlarla insan həlak olmağa başlayacaq.
Bakteriyaların antibiotiklərə rezistentliyinin formalaşmasının səbəbləri arasında:
- Qripp və kəskin respirator infeksiyaları zamanı antibiotiklərin tətbiqi. Virus infeksiyaları antibiotiklərlə müalicə olunmur. Lakin insanların bir çox hissəsi fikirləşir ki, qripp və virus infeksiyaları zamanı antibiotiklər tətbiq olunur. Bu çox təhlükəli yanılmadır.
- Antibiotiklərin həkimin təyinatı olmadan qəbulu. Bir çox insanlar özünə müstəqil şəkildə antibiotiklər "təyin edir". Bu da çox təhlükəlidir.
- Antibiotiklərin dozalarına və qəbul müddətinə ciddi riayət etməməsi. Bir çox insanlar vəziyyətində yaxşılaşma hiss etdikdən sonra antibotiklərin qəbulunu dayandırır, digərləri dərmanın dozasını azaldır və ya artırırlar. Bu qəti şəkildə yolverilməzdir.
- Antibiotiklərin "hər ehtimala qarşı", ciddi səbəbi olmadan təyini.
- Keyfiyyətsiz, beynəlxalq standartlara uyğun olmayan antibiotiklərin yayılması.
- Eyni antibiotiklərin xalq təsarüfatında və maldarlıqda istifadəsi.
Milli.Az












.png)


.jpg)

.jpg)











.jpg)






.png)





.jpg)



.png)




.jpg)


